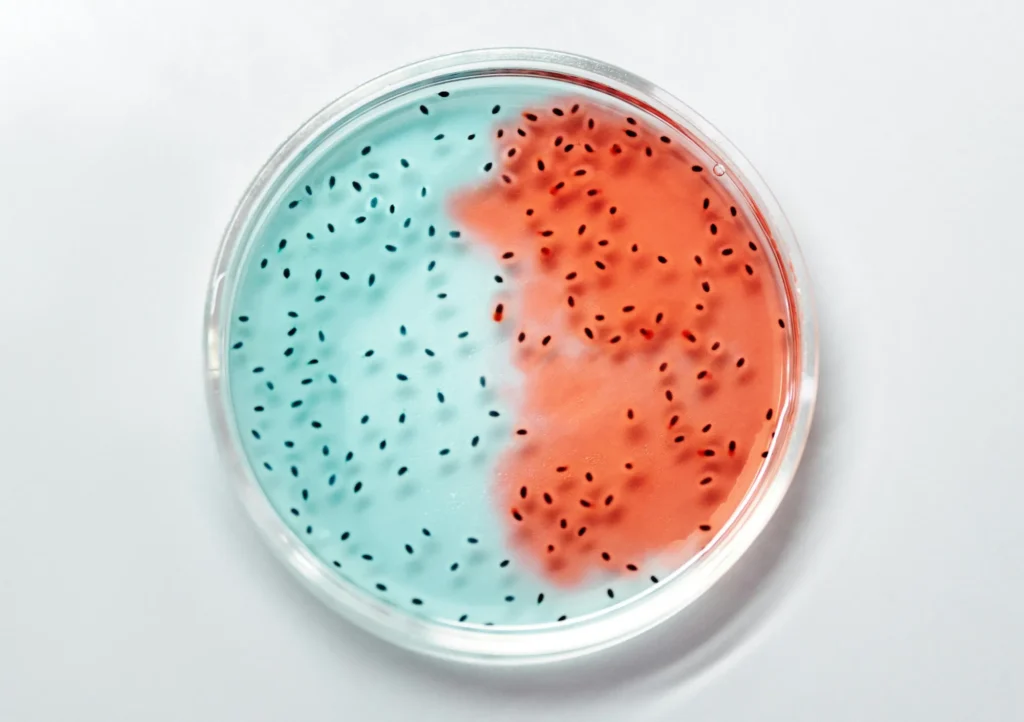
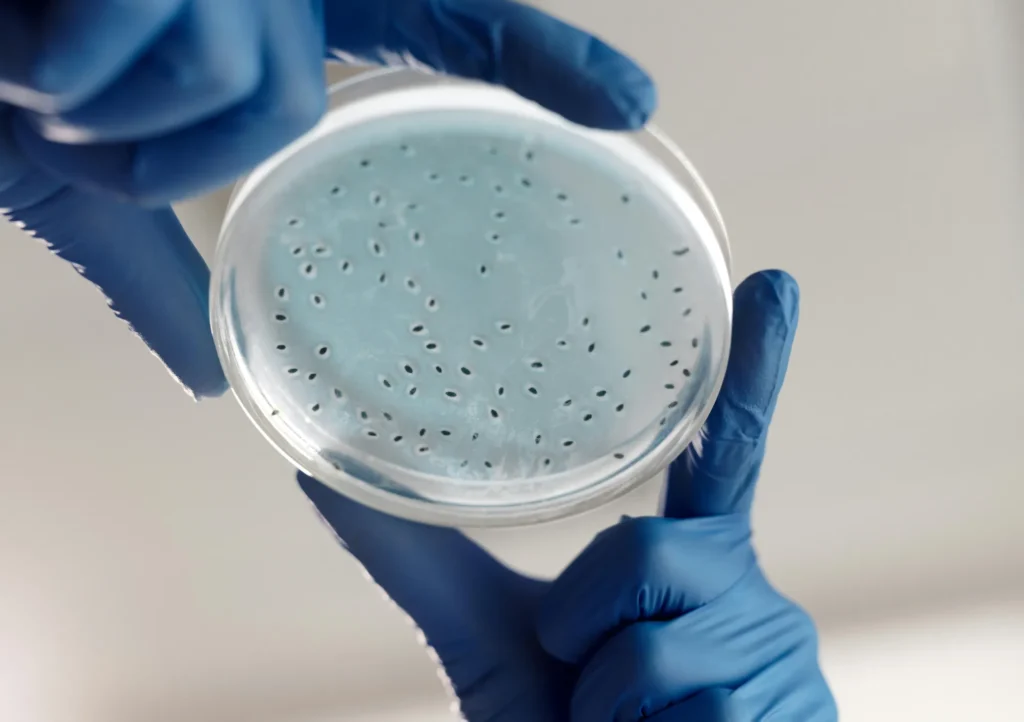

Clinique Vie – Microbiota, Nutrición y Bienestar

Clinique Vie – Microbiota, Nutrición y Bienestar
En Clinique Vie abordamos la salud desde el equilibrio interno. La microbiota y la nutrición juegan un papel fundamental en el bienestar digestivo, el sistema inmunitario, la energía, el estado de ánimo y la prevención de enfermedades. Por eso, ofrecemos estudios avanzados que permiten conocer en profundidad el funcionamiento de tu organismo y diseñar estrategias personalizadas para mejorar tu calidad de vida.
myBIOME – Secuenciación Completa de la Microbiota
Este estudio analiza en detalle el microbioma intestinal mediante secuenciación avanzada. Permite conocer la composición de las bacterias intestinales y su impacto en la digestión, la inmunidad, el metabolismo y la salud general.
EFMI – Estudio Funcional Terapéutico
El EFMI evalúa la actividad funcional de la microbiota intestinal, identificando desequilibrios que pueden afectar a la digestión, la absorción de nutrientes y el bienestar. Es una herramienta clave para orientar tratamientos personalizados.
Estudios de Clinique Vie para la Microbiota
Estudios de Nutrición Avanzada en Clinique Vie

Test Nutricional Avanzado
Evalúa el estado nutricional del organismo, detectando posibles carencias, desequilibrios y necesidades específicas para optimizar la salud.

Gestión del Peso
Programas personalizados basados en datos clínicos para mejorar la composición corporal de forma saludable y sostenible.

Wellness Check
Chequeo integral orientado al bienestar general, energía, metabolismo y prevención.

Aminoacidograma
Analiza los niveles de aminoácidos en el organismo, fundamentales para el metabolismo, la recuperación muscular y el equilibrio nutricional.

Ácidos Grasos (Suero y Eritrocitos)
Evalúa el perfil de ácidos grasos esenciales, importantes para la salud cardiovascular, cerebral e inflamatoria.

Mineral Hair Test
Analiza minerales y posibles tóxicos a través del cabello, proporcionando información sobre el equilibrio nutricional y la exposición a sustancias nocivas.

Perfil Vegano / Vegetariano
Estudio específico para personas con dietas veganas o vegetarianas, enfocado en detectar posibles déficits nutricionales y optimizar la alimentación.
Mejora tu bienestar desde el interior
Conocer tu microbiota y tu estado nutricional es el primer paso para mejorar tu salud de forma personalizada. En Clinique Vie te ayudamos a optimizar tu bienestar desde la ciencia, la prevención y el equilibrio interno.



